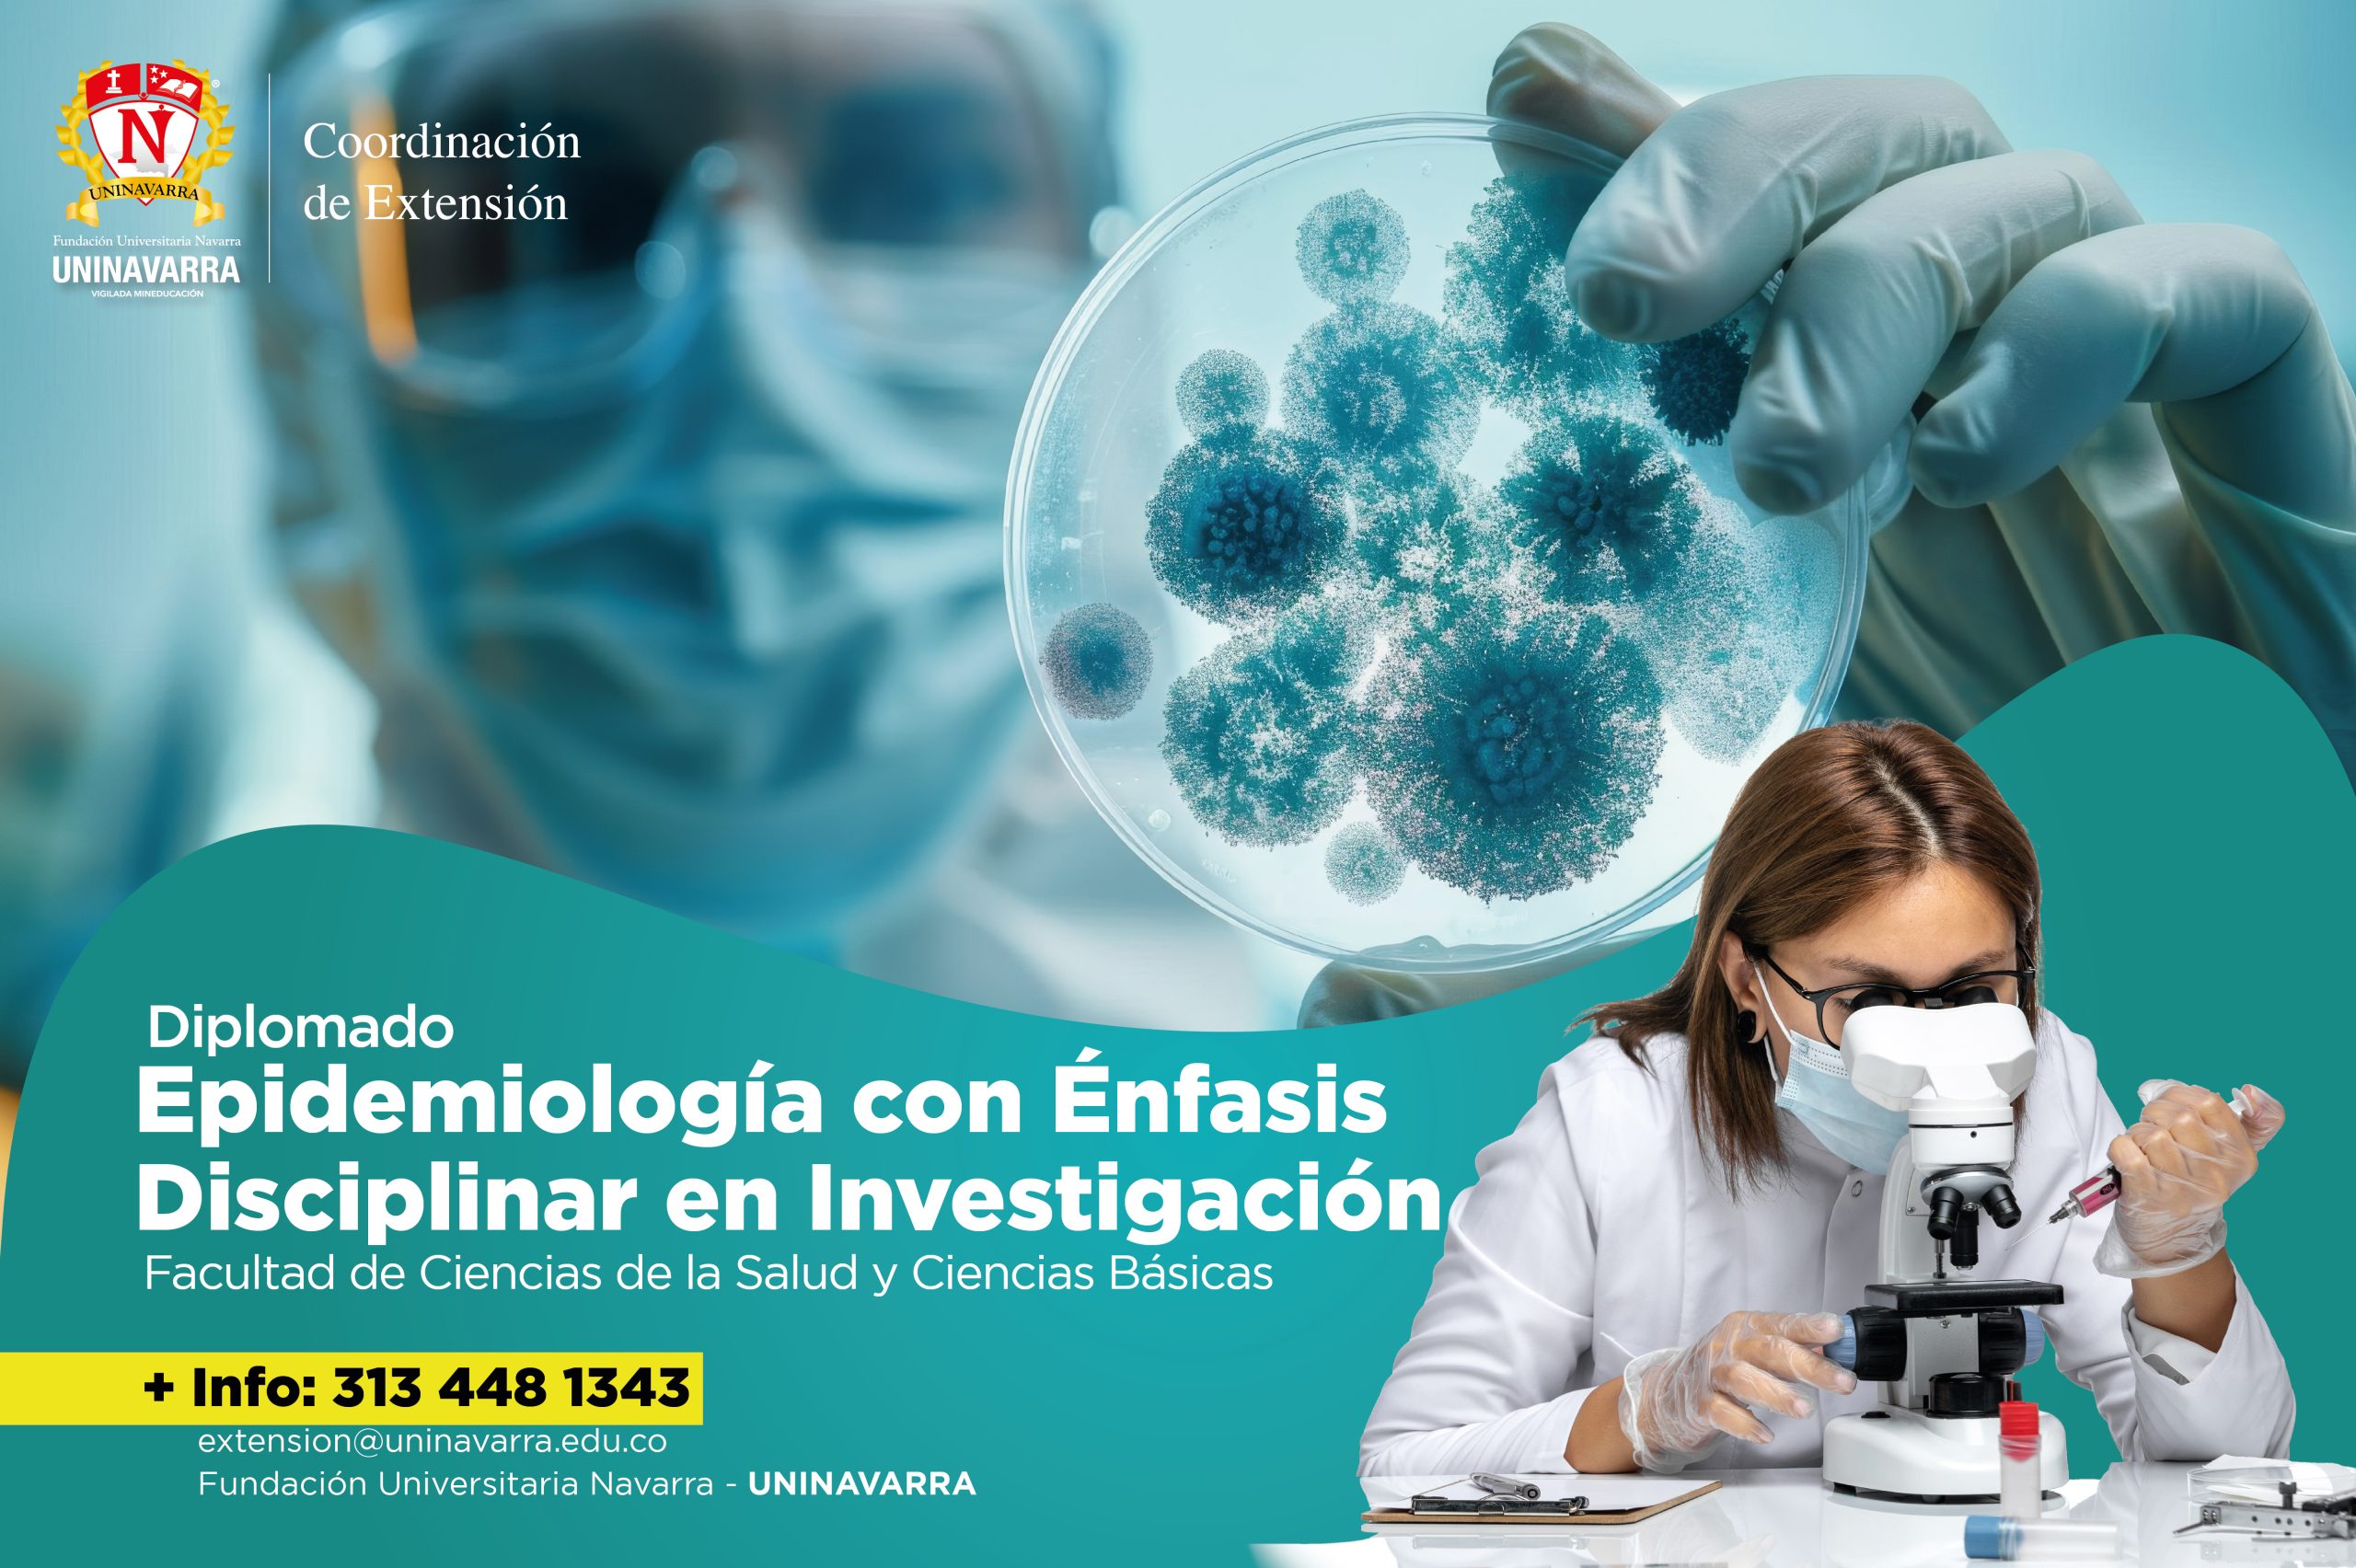

Diplomado - Epidemiología con énfasis disciplinar en investigación
Duración: 2 Meses
Intensidad Horaria: 120 horas
Inicio: Sujeto al número de inscritos
Finalización: Sujeto al número de inscritos
Inversión Comunidad en General:
Modalidad: Mixta
Cupos: Ilimitados
Certificación: Culminado el 100% del curso (Se entrega en un término de 48 horas)
Facultad: Ingenierías, Arquitectura y Urbanismo / Humanidades y Ciencias Sociales
Matrículas Generales: $1.200.000.00
Matrícula Convenios de Cooperación 20%: $960.000.00
Matrícula Docentes, Colaboradores y Egresados 30%: $840.000.00
Matrículas Estudiantes Uninavarra 40%: $720.000.00
Presentación del Programa
El Diplomado en Epidemiología con énfasis disciplinar en Investigación relaciona los temas sobre el uso de las prácticas en epidemiologia para la toma de decisiones clínicas como comunitarias y sociales, abarcando estrategias que permitan medir la frecuencia de eventos de interés en salud pública, investigación y sus consecuencias en los diferentes grupos poblaciones; la presencia o ausencia de entidades que afectan a la comunidad o el individuo y la probabilidad o no de sufrir dicha entidad además de reconocer los errores sistemáticos al realizar tanto las observaciones como las mediciones clínicas y epidemiológicas; y las diferentes formas que se pueden utilizar para controlarlas y tratar de establecer la relación de las posibles asociaciones causales entre los métodos diagnósticos y el pronóstico de las diferentes situaciones clínicas. Por lo tanto, se tienen en cuenta en el presente diplomado los modelos que explican el proceso salud-enfermedad con los principales factores que permiten localizar la salud pública desde el ámbito económico, social, político y cultural.
El Diplomado en Epidemiología con énfasis disciplinar en Investigación relaciona los temas sobre el uso de las prácticas en epidemiologia para la toma de decisiones clínicas como comunitarias y sociales, abarcando estrategias que permitan medir la frecuencia de eventos de interés en salud pública, investigación y sus consecuencias en los diferentes grupos poblaciones; la presencia o ausencia de entidades que afectan a la comunidad o el individuo y la probabilidad o no de sufrir dicha entidad además de reconocer los errores sistemáticos al realizar tanto las observaciones como las mediciones clínicas y epidemiológicas; y las diferentes formas que se pueden utilizar para controlarlas y tratar de establecer la relación de las posibles asociaciones causales entre los métodos diagnósticos y el pronóstico de las diferentes situaciones clínicas. Por lo tanto, se tienen en cuenta en el presente diplomado los modelos que explican el proceso salud-enfermedad con los principales factores que permiten localizar la salud pública desde el ámbito económico, social, político y cultural.
Objetivo
Proporcionar a los profesionales de la salud y carreras afines los conocimientos epidemiológicos básicos para el análisis de las patologías frecuentes de la sociedad actual para poder entender el proceso salud enfermedad de la comunidad en la que vivimos.
Proporcionar a los profesionales de la salud y carreras afines los conocimientos epidemiológicos básicos para el análisis de las patologías frecuentes de la sociedad actual para poder entender el proceso salud enfermedad de la comunidad en la que vivimos.
Metodología
• Conocer la terminología epidemiológica elemental para desarrollo de criterios de investigación en salud.
• Conocimiento básico de los datos epidemiológicos de las patologías más frecuentes de la población actual.
• Establecer los principales factores determinantes que permiten ubicar la salud pública desde el punto de vista económico, social, político y cultural.
• Analizar adecuadamente la información y los estudios epidemiológicos
• Proponer acciones en los niveles de prevención primaria, secundaria y terciaria a partir de la implementación de diferentes estrategias en salud.
• Ejecutar acciones de mejor a través de la toma de decisiones en beneficio de la salud pública.
• Conocer la terminología epidemiológica elemental para desarrollo de criterios de investigación en salud.
• Conocimiento básico de los datos epidemiológicos de las patologías más frecuentes de la población actual.
• Establecer los principales factores determinantes que permiten ubicar la salud pública desde el punto de vista económico, social, político y cultural.
• Analizar adecuadamente la información y los estudios epidemiológicos
• Proponer acciones en los niveles de prevención primaria, secundaria y terciaria a partir de la implementación de diferentes estrategias en salud.
• Ejecutar acciones de mejor a través de la toma de decisiones en beneficio de la salud pública.

